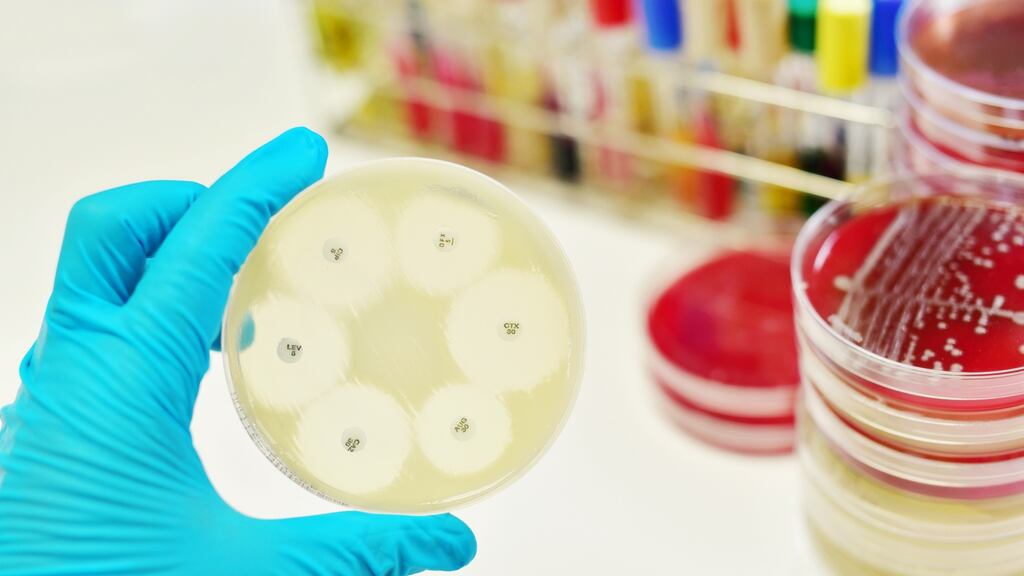
Plan will involve a  programme aimed at increasing prevention, surveillance and control of the spread of CPE

The Government is to put in place a new €20 million plan to tackle the spread of the hospital superbug, carbapenemase producing enterobacteriaceae (CPE).
The plan, which was approved by the Government before Christmas, will involve a three-year programme aimed at increasing prevention, surveillance and control of the spread of CPE.
Minister for Health Simon Harris said on Sunday that CPE continued to be a significant threat to the Irish health system. He said if it was not contained it "will have significant implications for healthcare delivery in Ireland".
In October 2017, Mr Harris declared the spread of CPE to be a national public health emergency.
The new plan, which will include CPE screening in hospitals and public awareness education and training, is being funded as part of the Government’s allocation to the Health Service Executive. Deficits in infection prevention and control are also to be addressed under the plan.
Mr Harris said the emergence of CPE was of serious global concern and that information showed there had been a rapid increase in incidence. He said CPE was first reported in Ireland in 2009 and the number of cases had increased in recent years. He said the need to address it "cannot be clearer".
The Minister said Ireland was are not starting from square one in addressing the challenge posed by CPE. He said the three-year plan provided the structure for tackling healthcare associated infections and antimicrobial resistance and built on the processes and procedures already in place for the provision of a safe health service.
“Experience in 2018 has also shown that significant improvements can also be achieved. Our task now is to continue in our focused work programme to this end.”